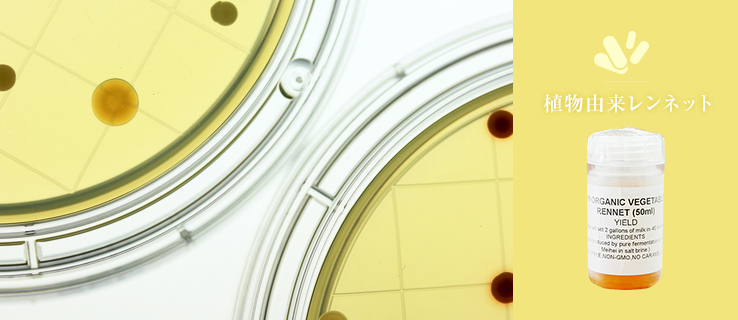
動物性レンネット

レンネットとは
レンネットをご存知ですか?チーズ作りに必要と言われていますが、詳しくはご存知ない方のほうが多いと思います。
レンネットを使えばご自宅でモッツアレラチーズも作れます。
今回はそんなレンネットについて詳しく解説していきます。
レンネットとは

レンネットとは、チーズを作る際に牛乳を固めるために使用する酵素剤のことです。
温めた牛乳に加えると、牛乳を凝固させ、チーズの素を生み出します。
- レンネット粉末(植物性レンネット)
- 家庭でのチーズづくりが盛んなトルコでつくられた植物性のレンネットです。
- 価格:680円(税込)
- 商品ページはこちら
レンネットは、まだ乳を飲んでいる哺乳動物の胃から抽出される「キモシン」という酵素を主成分にしています。
キモシンは、たんぱく質分解酵素「プロアテーゼ」の一種。
乳たんぱく質「kカゼイン」のなかで、105番目の「フェニノレアラニン」と106番目の「メチオニン」のペプチド結合を切断し、凝固させる作用を持ちます。

この作用を活用し、チーズ製造の過程において、レンネットは牛乳を凝固させる目的で使用されています。
モッツアレラチーズの作り方
自宅で手軽に作れるチーズのレシピをご紹介。
レンネットの誕生
レンネットの酵素は、もともと仔牛や子羊や山羊の胃袋に存在しています。
昔アラビアのとある旅の商人が、砂漠で仔羊の胃袋で作った水筒に
山羊のミルクを入れて持ち歩いていたそうです。
一日の旅を終えて、ミルクを飲もうと水筒を開けたところ、中のミルクが固まり、
柔らかなチーズができていました。
これは、仔羊の胃の中からしみだした凝固作用のある酵素が、山羊のミルクを固めたためです。
この酵素こそがレンネットであり、このことをきっかけとして、
レンネットを使ったチーズの製法が生まれたといわれています。
これは、仔羊の胃の中からしみだした凝固作用のある酵素が、山羊のミルクを固めたためです。
この酵素こそがレンネットであり、このことをきっかけとして、
レンネットを使ったチーズの製法が生まれたといわれています。

その後、この動物由来のレンネットは、チーズ作りにおいて長い歴史を持つヨーロッパで長年に渡り使用されてきました。
仔牛由来子牛の第4の胃から取り出した、伝統的な酵素)のレンネットはカーフレンネットと呼ばれています。
レンネットの種類
レンネットには抽出方法により、3つの種類があります。

チーズ作りにおける、世界でのレンネット使用割合は現在次のようになっています。
- ・動物由来レンネット : 10%
- ・植物性レンネット(微生物由来レンネット) : 45%
- ・遺伝子組換えレンネット : 45%
1.動物由来レンネット(カーフレンネット/ボバインレンネット。伝統的な酵素)
動物由来レンネットは、まだ哺乳中の牛や羊や山羊の第4の胃から抽出します。
6ヶ月までの月齢の仔牛から得られるレンネットを「カーフレンネット」、
6、7ヶ月以上の月齢の牛から得られるレンネットを「ボバインレンネット」と呼びます。
ボバインレンネットはカーフレンネットと比較すると、キモシンの含有量が低くなっています。
カーフレンネットは仔牛の月齢により、キモシンとペプシンの割合が異なります。
- ・生後3か月未満の仔牛(授乳又はミルク飼料):キモシン90%、ペプシン10%
- ・月齢6か月の仔牛(放牧及び授乳飼料):キモシン75%、ペプシン25%
- ・月齢6か月の仔牛(濃厚飼料):キモシン30%、ペプシン70%
生後3か月未満の仔牛から抽出されるカーフレンネットは、成分の90%以上が純粋なキモシンなため、
良質なチーズづくりに最適です。

カーフレンネットは主に仔牛の消化液から抽出されますが、
これは、仔牛を屠畜して胃を取り出すことでしか採取できません。
そのため、カーフレンネットを生産するためには、大量の仔牛を屠畜しなければならず、
酪農家には大きな負担となってきました。
このような事情で、カーフレンネットは生産できる量が限られており、
レンネットの中でも最も貴重なものとされています。
ただし、1980年代以降は動物愛護運動の影響により、カーフレンネットの供給量は減少するようになります。
現在では新たに、BSEの問題により、日本国内に輸入できるカーフレンネットは
オーストラリア産かニュージーランド産のレンネットだけとなっています。(2015年時点)

2.レンネット(微生物由来レンネット):酵母菌・担子菌・糸状菌・細菌などを発酵させ抽出
微生物レンネットと呼ばれます。
酵母菌や糸状菌、担子菌の培養液より、水などで抽出(または濃縮させて)つくります。
なかでも糸状菌である「MucorMiehei」は、キモシンの酵素作用によく似たアスパラギン酸プロテアーゼを産生します。
MucorMiehei由来の植物性レンネットはカーフレンネットと同様の働きがあり、
美味しいチーズ作りに役立ちます。
微生物レンネットは、主に錠剤や粉末状の形で販売されています。

微生物レンネットは、1960年頃からカーフレンネットの代替物として注目が寄せられるようになりました。
今まで使用していたカーフレンネットの代わりに、ケカビ(Mucor Pusillus)という黴から
レンネットの酵素を抽出するようになったのが始まりといわれています。
伝統的なチーズ作りの成分とは異なりますが、カーフレンネットと同様のキモシンを含み、
牛乳を凝固し美味しいチーズに仕上げてくれます。
その後、BSE問題が深刻化した2000年頃から2-3年のうちに、世界中でカーフレンネットから
微生物レンネット使用への移行が行なわれました。
現在では世界のレンネット生産率の割合の45%程度が微生物レンネットとなっています。
3.遺伝子組換えレンネット(GMO凝乳酵素):遺伝子組換え技術を応用

1980年代に発展した遺伝子組み換え技術(GMO)により、キモシン遺伝子のクローン化が可能になりました。
遺伝子組み換えレンネットは、仔牛キモシンとアミノ酸配列が同じであり、特性も同じであるといわれています。
さらに遺伝子組み換えレンネットは、キモシン酵素100%を実現できることから、均一的な純粋性を確保でき、
世界中で効率的なチーズ作りに活用されています。
**かわしま屋では遺伝子組換えレンネットは扱っておりません。**
どんなレンネットを使えばよい?
レンネットの形状

レンネットには、液体、粉末、タブレットといった形状があります。
いずれの形状のレンネットも、牛乳を凝固させるという目的ではどれでも問題なくご利用いただけます。
液体レンネットは、使用量を計測するのが最も簡単です。
一方で、粉末やタブレットのレンネットは、チーズ作りには適さない条件下においても、
比較的安定した凝固作用をもたらしてくれるという利点があります。
チーズ作りの材料や環境に応じて、使いやすいタイプのレンネットをお選びください。
レンネットの種類
カーフレンネット(仔牛の胃由来のレンネット)の成分は、たんばく質をしっかりと分解してくれるため、
長期間熟成させるチーズ作りに最も適しています。
植物性レンネットの場合、長期間熟成のチーズを作った場合、カーフレンネットで作ったチーズに比べて
ほんの僅かな苦味が生じるといわれています。
この僅かな苦味というのは、同じ牛乳と環境下で2種類のレンネットを使用してチーズを作り、
比較した場合です。
ただし、チーズの味そのものは、レンネットよりも牛乳やチーズ作りのプロセスによって
きく違いが出てくるものです。
どの種類のレンネットでも、キモシンの配合割合が同じであれば、
美味しいチーズ作りができるといえるでしょう。

チーズ作りにまつわるお役立ち情報
ここでは、チーズ作りに必要な乳酸菌や微生物の基礎知識や、
チーズにまつわるお役立ち情報をお届けします。
乳酸菌について
ミルクからは様々な食品が作られます。
例えばヨーグルトなどは乳酸菌が発酵することによって作られるものです。
この作用は昔から知られていることであり、ミルクの中の糖分が
乳酸に変わって酸味が出て来ることは古い文献にも記載されています。
チーズもヨーグルトのように乳酸菌の発酵で作られるものであり、
乳酸菌の発酵はチーズ作りの中で最も重要かつ、基本的な工程となっています。

乳酸菌は様々な場面で使用されるものですが、大きく分けて3つの場所で活躍しています。
- 1.ミルクに主に存在している乳酸菌。チーズやヨーグルトがこれに当てはまります。
- 2.果物や野菜などについている植物系の乳酸菌。 私たちの生活では漬物やしょうゆを作る際に使用されており、パンの発酵に使われる乳酸菌もこの種類に入ります。
- 3.人や動物などの腸内に住んでいる乳酸菌。便を作るのに役立ちます。腸内の乳酸菌が少なくなると便が出にくくなったり、体調を崩したりするため、非常に重要な役割を果たしています。
乳酸菌といってもその種類は非常に多く、それぞれ特性があります。
まずは温度です。40度で発酵を開始するもの、30度、20度で開始するものなど、
温度によって発行を行う乳酸菌があります。
例えば40度などの比較的温かい温度で発酵するものはクリーミーな風味を出すのに対して、
20度ぐらいの低い温度で発酵するものはシャープな風味がします。
また、乳酸菌によっては発酵と同時にアルコールや炭酸ガスを発生させる乳酸菌があります。
これらの特性を生かして、特徴のある乳製品作りが行われています。
チーズ作りでは、特にこれらの特性を生かして様々な種類のチーズが作られています。
酸乳チーズと呼ばれるものでは、主に乳酸菌は乳タンパク質を凝固させることが目的とされています。
レンネットチーズと呼ばれるチーズでは、ミルクのPHを調整して、
チーズの熟成を酵素のタンパク質を分解する力で作られます。
チーズ作りに用いられるカビとそのほかの微生物
あえてカビをつけて作られるチーズがあります。
日本でも有名なのは白カビのカマンベール、青カビのブルーチーズですが
これらはなぜカビをつけて作られるのでしょうか。
その理由としては、カビの特性があります。
カビの力としてはタンパク質や脂肪を分解させる力があります。
それらを分解する際に出る香りがブルーチーズやカマンベールチーズの独特な風味を作っています。

また、どんなカビでも良いとは限りません。
人体に悪影響を与えるカビもありますので、
青カビや白カビ、ゲオトリカムと呼ばれるカビ以外の場合は、取り除くようにしましょう。
ブルーチーズには穴があけられていますが、これにはきちんとした理由があります。
カビは空気を必要とするからです。
空気がチーズ全体に行きわたるように穴をあけて空気の通る穴を作っているのです。
チーズにはこのようにカビをつけて作られるものもありますが、
カビ以外にも使われている微生物はあります。
例えばライネンス菌と呼ばれる菌を付けて作られるチーズ。
ライネンス菌は非常に強いタンパク質の分解能力があり、
チーズに独特の風味とオレンジ色、茶色などの被膜を作る効果があります。
このライネンス菌を使う場合は、菌を増加させるために表面を塩水で洗い流すことから
ウォッシュチーズと呼ばれています。
こういったように菌を付けて作られるチーズの種類は多く、
乳酸菌だけで作られるチーズよりも独特の風味があり愛好者もいます。
やみつきのチーズとも言えるでしょう。
風味の他にも固さも変えることができますので、とろけるような柔らかさをもつチーズから、
歯ごたえのある固めのチーズまで様々な食感で楽しむことができます。
菌の為に穴を空けるタイプのチーズがありますが、反対に菌がチーズに穴を空けるものもあります。
プロピオン菌と呼ばれる菌を使ったチーズがその代表格であり、
プロピオン菌は製造過程でチーズに穴を空けます。
その理由としては、プロピオン菌は増加すると炭酸ガスとプロピオン酸、酢酸を作り出して
穴を空けるのです。
これらの穴の事をチーズアイと呼び、2~3センチほどの穴を作り出します。
こういったチーズはスイスタイプのエメンタールチーズなどに見られる特徴です。
チーズの種類と分類

チーズは古来から作られているものや、近年新しく作られだしたものなど様々な種類があります。
日本ではおおよそ20種類(クリームチーズ、カッテージチーズ、クワルク、マスカルポーネ、モッツァレラ、ストリング、リコッタ(ホエーチーズ)、ゴーダ、エダム、チェダー、カマンベール、ブリー、ブルーチーズなど)が有ります。
世界では、なんと400種類以上ものチーズが作られています。
まだまだ知られていないチーズを含めるとその数は1000種類程度あるとも言われています。
これらのチーズの分類は以前は、産地や原材料、製造方法などで分類されてきました。
しかし、これだけの分類方法では膨大な種類のチーズを区分けしにくくなってきたので、
現在では水分量、脂肪分、乳成分、熟成の特性などチーズ自体の特性で分類されています。
分類1.チーズの水分量で分類する
チーズにとって水分量は非常に重要な役割をしています。水分量が多ければそれだけ柔らかく口あたりの良いチーズになりますが、
反対に水分量が少なければ歯ごたえのあるチーズになります。
柔らかいチーズなどはサラダなどと一緒に食べられたり、熱を加えて溶かしながら食べることもできます。
特別硬いチーズでは削ってパスタに乗せたり、そのまま食べられることは少ないです。
軟質チーズ、半軟質チーズ、半硬質チーズ、硬質チーズ、特別硬質チーズの5段階に分けられます。
分類2.チーズの脂肪量で分類する
脂肪量によっても分類されます。脂肪量が多いとクリーミーでまろやかな味わいのチーズになり、
脂肪量が少ないとさっぱりとしたチーズになります。
最近では脂肪を抜いた脱脂乳チーズなどもあります。
分類3.チーズの熟成方法で分類する
熟成とはカビなどの菌を使用したものを言います。
つまり乳成分の発酵のみで作られているものは熟成をしていないと分類されますので非熟成と呼ばれます。
乳成分でも熟成酵素を利用したものは細菌内部熟成と呼ばれます。
菌を使用する場合は主に3つの菌で分類、表面か内部かの2種類で分類されます。
3つの菌は青カビ、白カビ、ライネンス菌です。表面のみに熟成させているのか、内部に熟成させているのかです。
これでほぼ全てのチーズが分類されると言われています。
| チーズの名前 | 水分量 | 脂肪量 | 熟成方法 |
|---|---|---|---|
| カッテージ | 軟質 | 低脂肪 | 非熟成チーズ |
| モッツァレラ | 半軟質 | 中脂肪 | 非熟成チーズ |
| カマンベール | 軟質 | 全脂肪 | カビ表面熟成チーズ |
| クリームチーズ | 軟質 | 高脂肪 | 非熟成チーズ |
| チェダー | 硬質 | 全脂肪 | 細菌内部熟成チーズ |
| パルミジャーノ・レッジャーノ | 特別硬質 | 中脂肪 | 細菌内部熟成チーズ |
| ゴーダ | 半硬質 | 全脂肪 | 細菌内部熟成チーズ |
| ロックフォール | 半硬質 | 全脂肪 | カビ内部熟成チーズ |
| サンポーラン | 半硬質 | 全脂肪 | 細菌表面熟成チーズ |
| エダム | 硬質 | 中脂肪 | 細菌内部熟成チーズ |
| ストリング | 半硬質 | 全脂肪 | 非熟成チーズ |
| フェタ(ギリシャのチーズ) | 軟質 | 全脂肪 | 非熟成チーズ |
レンネットおすすめ商品
チーズ作りにおすすめのかわしま屋取扱い商品をご紹介いたします。
レンネット粉末(植物性レンネット)1g-100Lの牛乳をチーズにできます-【送料無料】*メール便での発送*【再入荷未定】
手軽に美味しいチーズづくりが楽しめる。レンネットの本場トルコ製の上質なレンネットです。最大100Lの牛乳をチーズにできます
630 円(税抜)
\初回購入で300ポイントGET!/
かわしま屋の商品を見る >>



もくじ